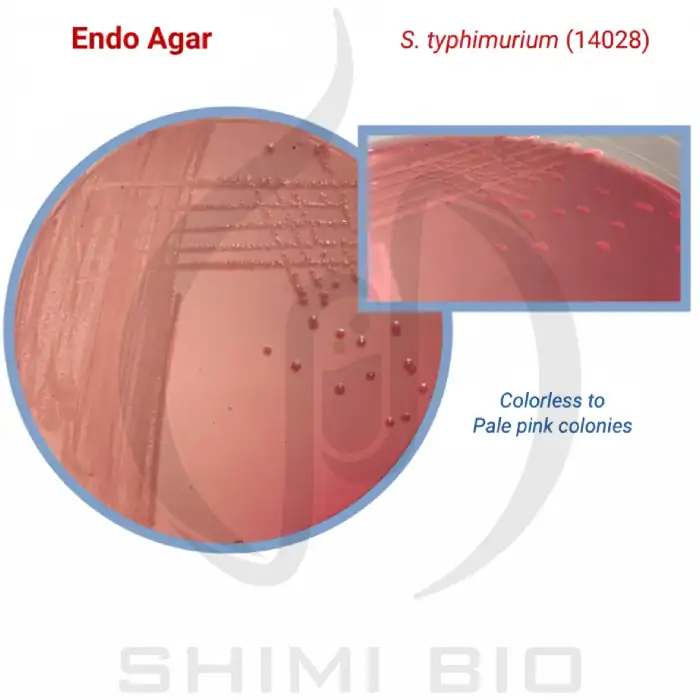
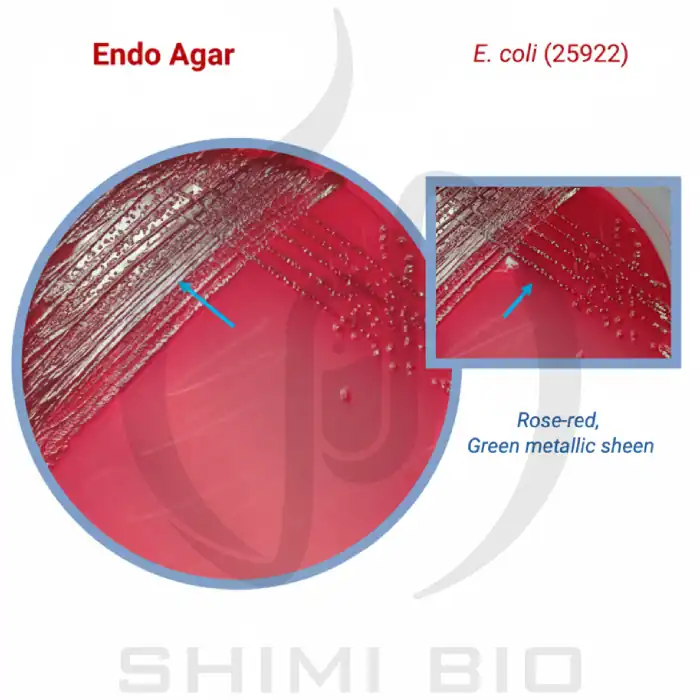

محیط کشت اندو آگار ایبرسکو
-
شناسایی دقیق کلیفرمها
-
افتراق سریع لاکتوز مثبتها
-
مهار رشد گرم مثبتها
-
رنگ شاخص واضح و پایدار
-
مناسب برای کنترل کیفی
-
پودر یکنواخت با حلشوندگی عالی
محصول موجود است.
محیط کشت اندو آگار ایبرسکو، یک محیط انتخابی و افتراقی است که برای جداسازی و شناسایی باکتریهای گرم منفی رودهای، بهویژه گونههای کلیفرم (Coliform) از نمونههای آب، مواد غذایی و ادرار استفاده میشود.
این محیط بر اساس تخمیر قند لاکتوز و تغییر رنگ شاخص Basic Fuchsin عمل میکند و رشد باکتریهای گرم مثبت را مهار مینماید.
جهت مشاهده ی محیط کشت های میکروبی روی لینک کلیک کنید.
ویژگیهای محیط کشت اندو آگار ایبرسکو
| ویژگی | مقدار / توضیح |
|---|---|
| نام محصول | Endo Agar |
| برند | Ibresco – ایران |
| نوع محیط | جامد (Agar) |
| نوع محیط از نظر عملکرد | انتخابی و افتراقی |
| رنگ پودر | یکنواخت با ذرات تیره |
| رنگ محیط آماده | صورتی تا قهوهای مایل به زرد |
| حالت فیزیکی | پودر خشک و همگن |
| pH نهایی (در 25°C) | 7.5 ± 0.2 |
| مقدار مصرف | 41.5 گرم در 1 لیتر آب مقطر |
| دمای اتوکلاو | 121°C به مدت 15 دقیقه |
| دمای نگهداری پودر | زیر 30°C |
| دمای نگهداری محیط آماده | 2 تا 8°C |
| ماندگاری | تا پایان تاریخ درجشده روی بسته |
فرمول شیمیایی (گرم بر لیتر)
| ترکیب | مقدار (g/L) |
|---|---|
| Peptone | 10.0 |
| Lactose | 10.0 |
| Di-Potassium Phosphate | 3.5 |
| Sodium Sulphite | 2.5 |
| Basic Fuchsin | 0.5 |
| Agar | 15.0 |
طرز تهیه محیط کشت اندو آگار ایبرسکو
-
قوطی پودر محیط را به خوبی تکان دهید.
-
41.5 گرم از پودر را در 1 لیتر آب مقطر حل کنید.
-
محلول را گرم کنید تا کاملاً حل شود.
-
در دمای 121°C به مدت 15 دقیقه اتوکلاو کنید.
-
محیط را تا 50°C خنک کنید و در پتریدیشهای استریل بریزید.
عملکرد محیط و نحوه استفاده
محیط Endo Agar برای افتراق باکتریهای گرم منفی بر اساس توانایی تخمیر لاکتوز طراحی شده است:
-
باکتریهای لاکتوز مثبت (مانند Escherichia coli) کلنیهایی به رنگ قرمز مایل به صورتی با جلای فلزی سبز ایجاد میکنند.
-
باکتریهای لاکتوز منفی (مانند Salmonella و Shigella) کلنیهایی بیرنگ یا صورتی کمرنگ تشکیل میدهند.
در این محیط، سدیم سولفیت و بازیک فوکسین بهصورت انتخابی رشد باکتریهای گرم مثبت را مهار میکنند.
کاربردهای محیط Endo Agar
1. تشخیص باکتریهای کلیفرم در آب و مواد غذایی
برای شناسایی آلودگی باکتریایی در نمونههای آب، نوشیدنیها و مواد غذایی فرآوریشده.
در این مسیر تشخیصی، علاوه بر اندو آگار، محیط کشت EMB ایبرسکو هم کاربرد دارد.
2. بررسی آلودگی ادرار و نمونههای بالینی
در آزمایشگاههای میکروبیولوژی برای شناسایی گونههای E. coli و Klebsiella در نمونههای ادرار و ترشحات بدن.
در بررسی نمونه های بالینی، در کنار اندو آگار محیط کشت بلاد آگار ایبرسکو هم مصرف می شود.
توصیه می کنیم که آن را هم تهیه نمایید.
3. کنترل کیفی فرآوردههای دارویی و آرایشی
بهمنظور اطمینان از عدم وجود باکتریهای گرم منفی و کلیفرمها در محصولات دارویی و بهداشتی.
یکی دیگر از محیط هایی که در این فرآیند کنترلی مصرف می شود، محیط کشت تایوگلیکولات براث ایبرسکو است.
بهتر است که مشخصات آن را هم بررسی کنید.

کنترل کیفی محیط
| رنگ کلنی | رشد | ATCC | ارگانیسم |
|---|---|---|---|
| قرمز رز با جلای سبز متالیک | خوب | 25922 | Escherichia coli |
| صورتی تا قرمز روشن | ضعیف تا متوسط | 29212 | Enterococcus faecalis |
| صورتی تا قرمز موکویید | خوب | 33495 | Klebsiella pneumoniae |
| بیرنگ تا صورتی کمرنگ | خوب | 14028 | Salmonella Typhimurium |
در روند کشت باکتری ها، همیشه پتری دیش و کیفیت و استریل بودن آن یکی از ارکان اساسی بوده است.
پیشنهاد می کنیم به صفحه ی خرید پتری دیش بروید و برند و سایز مد نظر خود را انتخاب کنید.
نکات ایمنی و نگهداری
-
پودر محیط جاذب رطوبت است؛ در محیط خشک نگهداری شود.
-
از تماس مستقیم با نور خورشید پرهیز شود.
-
هنگام کار با محیط، از دستکش و ماسک آزمایشگاهی استفاده کنید.
-
تنها برای استفاده تحقیقاتی و تشخیصی مجاز است.








